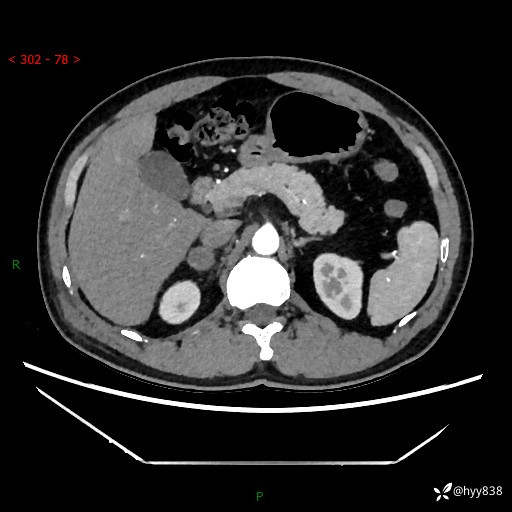
img
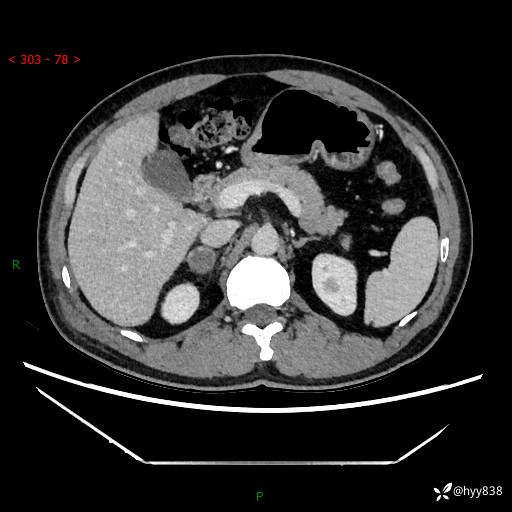
img

年龄男性,发现右侧肾上腺占位6天。有难度,挑战下---(有结果)
胡志勇HZY 达人已点赞病例信息
性别:男
年龄:38岁
主诉:发现右侧肾上腺占位6天
现病史:患者9月4日摔伤在深圳市宝安区中心医院行CT检查提示右侧肾上腺区结节(38*27mm),复查B超提示右侧肾上腺区可见一61*24mm异常低回声团,建议进一步检查。进一步完善增强CT后提示:右侧肾上腺区肿块及周围渗出改变,大致同前,考虑肾上腺腺瘤,不除外瘤内出血可能,否认阵发性头晕、头痛、出汗、乏力等不适,门诊以“ 右侧肾上腺肿瘤”收入住院。 起病来,患者精神、食欲、睡眠可,大便通畅,小便如上述,体力体重无明显改变。
肾上腺CT平扫













增强(动脉期+静脉期)

问题与讨论
单侧肾上腺病变,鉴别诊断有哪些















































